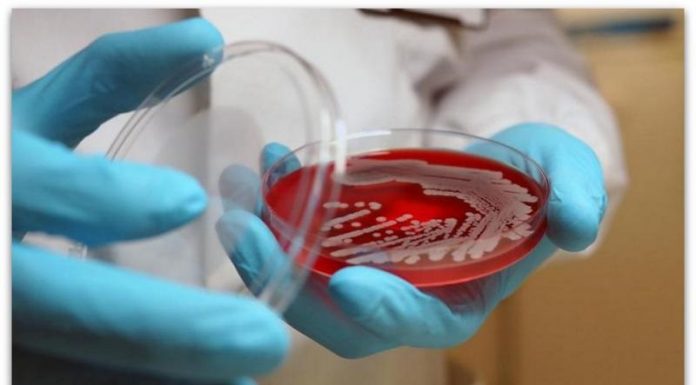

Припадниците на машкиот пол од човечкиот род се многу необични затоа што спаѓаат во само шест проценти цицачи кај кои татковството има големо значење.
И уште повеќе од тоа, нивното однесување и грижата за новороденчето можат да се изедначат со оние кои се појавуваат кај мајките. Затоа научниците се запрашале дали улогата на татко може на некој начин да влијае врз мозокот на мажот?
Последните години е спроведен поголем број научни испитувања кои се занимаваат со ова прашање, а стручњаците утврдиле дека по раѓањето на детето кај мажите се случуваат значајни невролошки и хормонски промени – слични на оние кои го доживуваат и мајките.
Еве што се одвива во мозокот на младите татковци.
Мозокот на таткото изгледа како мозокот на мајката
Грижата за бебето го менува мозокот на мажите, па тој покажува поинакво когнитивно и емотивно однесување. Дури и мозокот на таткото сѐ повеќе личи на мозокот на мајката. Едно истражување кое било спроведено неодамна покажало дека мажите кои ги чуваат своите деца покажуваат интересни резултати на скенирањето на мозокот. Имено, во нивниот случај, деловите од мозокот задолжени за обработка на емоциите и социјалното разбирање се изразено активни откако бебето ќе стане дел од нивниот живот.
И татковците минуваат низ хормонски промени
Бременоста, породувањето и доењето предизвикуваат намалено или засилено лачење на одредени хормони кај жените, но научниците утврдиле дека нешто слично се одвива и во телата на мажите. Истражувањата во кои учествувале и луѓе, но и припадници на животинскиот свет покажале дека мажите кои се реализирале во улога на родители имаат повеќе окситоцин, естроген, пролактин и глукокортикоиди, а стручњаците наведуваат дека до ова зголемување доаѓа благодарение на контактот со бебето и неговата мајка.
Окситоцинот ја засилува врската помеѓу татковците и бебињата
Веќе споменатиот окситоцин, кој се нарекува уште и љубовен хормон, ги поттикнува татковците да се грижат повеќе за своите бебиња и за нивната нега, да се вклучат во игра со нив, а децата им возвраќаат со еднаква љубов.
Татковството е причина за создавање на нови неврони
Како што покажале бројни наулни истражувања, нервните клетки на татковците се обновуваат, а исто така, доаѓа и до создавање на нови. Освен тоа, тие растат побрзо и подобро се развиваат, што ја подобрува меморијата на мажите.
Татковците се чувствителни на детскиот глас
Општо е познат мајчинскиот инстинкт кој им помага на мајките да препознаат кога плачењето значи дека е бебето гладно, кога нешто го боли, а кога е поспано. Меѓутоа, научниците утврдиле дека и татковците умеат да се поврзат со своите деца на тој начин: едно истражување покажало дека дури 90 отсто од татковците го препознава значењето на плачот на бебето!